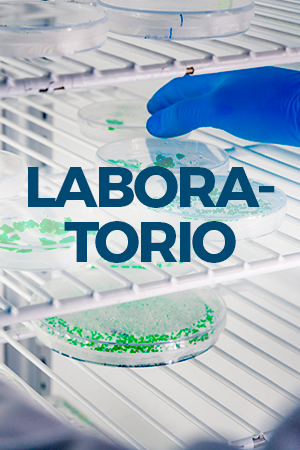

NOSOTROS
Medicorp, es una empresa mexicana especializada en la comercialización de equipos médicos, de laboratorio, científico e investigación, equipo para laboratorios industriales para sectores estratégicos en el país.
La compañía inició operaciones en 1991 bajo el nombre de Medicorp en Texas, Estados Unidos, operando como mayorista para distribuidores en distintos estados de la República Mexicana y colaborando con instituciones del sector salud como ISSSTE, SSA y IMSS, así como distribuidores en varios estados de la República Mexicana.

En 1997 se estableció una oficina de ventas en Guadalajara para atender la región occidente del país e iniciar la importación directa de equipos para su comercialización en territorio nacional.
En 2015 se formaliza la operación en México como Medical Equipment and Disposables de México S.A. de C.V., fortaleciendo su presencia en el mercado nacional, participando en proyectos llave en mano, atención directa a entidades gubernamentales y colaboración con integradores de tecnología médica.
En 2018 la empresa trasladó sus oficinas comerciales a Naucalpan, Estado de México, consolidando su operación y capacidad de atención a nivel nacional.
A lo largo de su trayectoria, la organización se ha enfocado en proveer soluciones para hospitales, laboratorios y las industrias farmacéutica, alimenticia e industrial en todo México, ofreciendo equipos de marcas líderes a nivel global y garantizando altos estándares de calidad, servicio y confiabilidad.
ATENDEMOS A:
HOSPITALES
Y CLÍNICAS
LABORATORIOS
ESPECIALIZADOS
FARMACÉUTICA
Y ALIMENTICIA
SECTOR
INDUSTRIAL
FABRICANTES DE
PINTURA
NUESTRO COMPROMISO
En Medicorp impulsamos la operación segura, eficiente y confiable de instituciones de salud, laboratorios y hospitales mediante soluciones especializadas que cumplen con los más altos estándares de calidad, normatividad y tecnología médica.
Somos sinónimo de confianza, innovación y respaldo. Trabajamos como aliados estratégicos de nuestros clientes, proporcionando soluciones que impactan directamente en la calidad del cuidado médico, la continuidad operativa y la seguridad de los procesos clínicos y científicos.
NUESTRA FORMA DE TRABAJO
Trabajamos con constructoras e integradoras en proyectos llave en mano y atendiendo a distribuidores en los distintos estados de la República Mexicana.
Funcionamos como mayoristas desde nuestras oficinas en USA, dando apoyo técnico a nuestros distribuidores en licitaciones o proyectos especiales.
Contamos con servicio de mantenimiento preventivo, correctivo y garantía a todos los equipos que distribuimos.
CATÁLOGOS DE MARCAS

NUESTRA MISIÓN
Atender las necesidades de todos nuestros clientes en tiempo y forma, proveyendo con equipo médico, científico y de laboratorio de alta calidad global y alta tecnología, para facilitar su labor de investigación, brindando una alta calidad de servicio al cliente y sus productos.
NUESTRA PROPUESTA DE VALOR
- Equipos de alto desempeño y calidad certificada a nivel global.
- Soluciones integrales para cadena de frío, soluciones para microbiología hasta 300º C y autoclaves de vapor de alta y baja temperatura.
- Asesoría técnica especializada
- Cobertura nacional y atención personalizada
- Experiencia en proyectos para sectores regulados
- Instalación y puesta en marcha de los equipos que manejamos.
- Capacitación para los equipos que manejamos
- Pólizas de servicio anual.
- IQ, OQ y PQ.
UBICACIÓN Y CONTACTO
¿Tienes alguna consulta o requieres una cotización? En Medicorp te atendemos con rapidez y profesionalismo. Encuéntranos en nuestra ubicación o escríbenos y un especialista se pondrá en contacto contigo a la brevedad.
OFICINA DE VENTAS
Luis Cabrera 104, Cto. Economistas, Cd. Satélite, Naucalpan, Méx. 53100
- +52 55 8661-0830
- +52 55 5373-5779